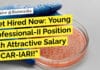
Get Hired Now: Microbiology Position with Attractive Salary at ICAR-IARI! ICAR-IARI Molecular Biology Young Professional Job - Apply Now

Merck MSc Biotech, Biochem, Life Sciences & Microbiology Application Senior Expert Job
Merck MSc Biotech, Biochem, Life Sciences & Microbiology Application Senior Expert Job
Merck MSc Biotech, Biochem, Life Sciences & Microbiology Application Senior Expert Job. MSc...
Illumina CEO’s Surprise Exit Shakes Up Gene Sequencing World
Illumina CEO's Surprise Exit Shakes Up Gene Sequencing World
Francis deSouza, the chief executive of Illumina, has resigned from his position following a contentious proxy...
Pepsico Food Safety Scientist Job Opening, Apply Online
Pepsico Food Safety Scientist Job Opening, Apply Online
Pepsico Food Safety Scientist Job Opening, Apply Online. Interested and eligible candidates can check the details and...
MSc Food Tech, Food Sciences Candidates Apply at Pepsi For Senior Scientist – R&D...
Pepsi R&D Senior Scientist Job For MSc Food Tech, Science - Apply Online
Pepsi R&D Senior Scientist Job For MSc Food Tech, Science - Apply...
Aravind Medical Research Foundation (AMRF) JRF Recruitment, Apply Online
Research Fellow Vacancy AMRF, Aravind Medical Research Foundation
Aravind Medical Research Foundation (AMRF), Madurai is a multidisciplinary research institute, recognized as a Scientific and Industrial...
MSD BSc Biology, Biochem & Life Sciences Associate Specialist Job, Apply Online
MSD BSc Biology, Biochem & Life Sciences Associate Specialist Job, Apply Online
MSD BSc Biology, Biochem & Life Sciences Associate Specialist Job, Apply Online. MSD...
Labcorp BSc & MSc Life Sciences QC/Data Entry Associate Job – Candidates With 0-2...
Labcorp QC/Data Entry Associate Job - BSc, MSc Life Sciences Apply Online
Labcorp QC/Data Entry Associate Job - BSc, MSc Life Sciences Apply Online. BSc...
Looking For Trainee Opportunity? Colgate-Palmolive Is Hiring – Apply Online If You Fit...
Colgate-Palmolive Research Trainee Microbiology, Apply Online
Colgate-Palmolive Research Trainee Microbiology, Apply Online. Looking For Trainee Opportunity? Colgate-Palmolive Is Looking - Apply Online If You Fit...
Cytiva Scientist Job For Microbiology Candidates – Apply Online
Cytiva Scientist Job For Microbiology Candidates - Apply Online
Cytiva Scientist Job For Microbiology Candidates - Apply Online. MSc Microbiology Scientist Job at Cytiva. Cytiva...
CSIR-IICT MSc, MTech, BTech, BSc & PhD Life, Biological Sciences, Genetics, Microbiology Project Jobs
IICT Project Jobs Biotech, Biochem, Life Sciences - Attend Walk-In
IICT Project Jobs Biotech, Biochem, Life Sciences - Attend Walk-In. CSIR Indian Institute of Chemical...
DST WIDUSHI Programme For Senior Women Scientists In Life Sciences – Apply Now
DST WIDUSHI Programme For Senior Women Scientists In Life Sciences - Apply Now
DST WIDUSHI Programme For Senior Women Scientists In Life Sciences - Apply...
Biotecnika Times Newsletter 09.06.2023 Summer Internship CUH, Non-NET Job Opportunities, Pfizer & Sanofi Hiring
Biotecnika Times Newsletter 09.06.2023 Summer Internship CUH, Non-NET Job Opportunities, Pfizer & Sanofi Hiring
Summer Internship (SSR) Scheme of DST-SERB at CUH, Applications Invited...
Groundbreaking CRISPR Therapy Set to Revolutionize Healthcare: FDA Nears Approval Decision
Groundbreaking CRISPR Therapy Set to Revolutionize Healthcare: FDA Nears Approval Decision
The field of gene editing has witnessed remarkable advancements over the past decade, with...
CSIR-IMTECH Molecular Biology Project Associate Job, Apply Online
CSIR-IMTECH Molecular Biology Project Associate Job, Apply Online
CSIR-IMTECH Molecular Biology Project Associate Job, Apply Online. Interested and eligible applicants can check out all of...
Pfizer Life Sciences Associate Job Opening, Apply Online
Pfizer Life Sciences Associate Job Opening, Apply Online
Pfizer Life Sciences Associate Job Opening, Apply Online. Pfizer is hiring candidates for an Associate I –...